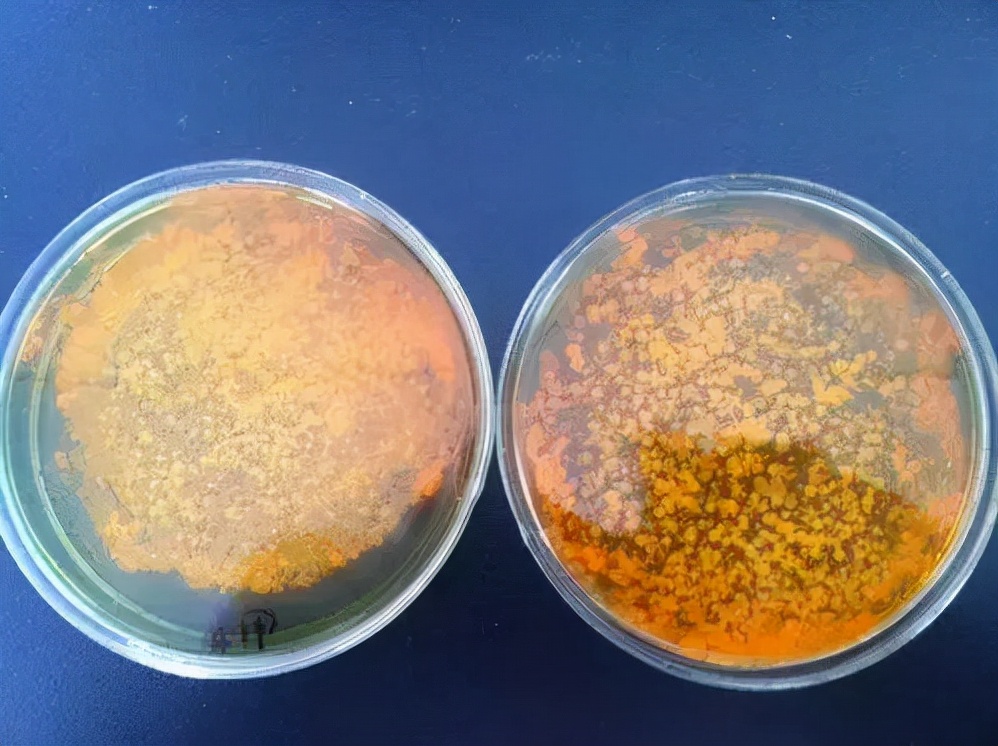
白露养虾的正确方法,白露节水产养殖方法

“白露秋分夜,一夜冷一夜”,白露是二十四节气中的第十五个节气,是反映大自然气温变化的节令。 白露过后天气逐渐转凉,是除清明节气外,一年中第二个对虾发病的高峰季节,因此,养殖户朋友们要匹配有效的养殖技术和方法,加强虾塘的管理和病害防治,让对虾顺利渡过这个难关。

“白露”气候对虾常见养殖问题
1、倒藻或转水:
气温下降,光照减弱,暴雨等造成水体环境因子发生改变,诱发倒藻,出现悬浮颗粒,耗氧严重,氨氮、亚盐超标。在连续阴雨过程中,光照不足,水体营养结构发生变化,优势藻种轮替,容易发生转水,甚至出现不良藻相。

2、弧菌大量滋生:
昼夜温差和大量雨水导致池塘上下水体对流强烈,会带起池底的残饵粪便、死藻颗粒等,引发池塘溶氧不足,造成虾塘水质底质恶化,利于弧菌的生长繁殖,虾子易出现黄黑鳃、空肠胃、偷死等问题,晴雨反复或大雾时更为明显。
3、虾应激发病:
降温和暴雨使得水体温度、盐度和PH等发生变化,虾子应激出现蜕壳或活力减弱,此时虾免疫力低下。若再遇到水质恶化或摄食到黏附有弧菌的有机颗粒,就极易引起慢料、空肠胃、软壳偷死。

“白露”时节,对虾病害防治“三板斧”
改底稳水 + 控料保健 + 催肥防病 = 高产高效益
第一招:改底稳水
长时间的残饵、饲料、粪便累积,池底中的有机物增多,化学耗氧量陡增,温度骤降,藻类老化,有益藻类得不到有效繁殖,有害病原菌繁殖过快。
“白露”期间可以通过换水、生石灰水调控和氯制剂杀灭来去除老化藻类,减少底部氧债。同时,进行补肥和补菌,预防藻类应激倒藻。此时菌种宜选择乳酸菌、酵母菌等。
第二招:控料保健、防应激
日照时间减弱,昼夜温差大,对虾食欲不强烈。同时,天气变化多,常引起水体温度、盐度、PH值、氨氮和亚盐等水质指标的变化,对虾发生应激。
内服强体突出肝肠一体防控,护理肠道可选择拌喂乳酸菌、丁酸梭菌等。保肝护肝选择龙昌胆汁酸,促进肝胰腺发育,维护肝胰腺健康,同时提高抗病能力。
当发生暴雨、倒藻时及时进行防应激,尽快泼洒维生素C防应激处理,晚上泼洒增氧剂进行增氧。倒藻时,还需另外泼洒表面活性剂,打破水体表面张力,防止水体分层。
第三招:催肥防病
养殖后期,养殖病害高发,白鹭乱飞,疾病传播非常快,一个星期使用一次碘制剂进行杀菌预防,预防对虾空肠空胃、黄腮黑腮、黄腿黑脚等症状。